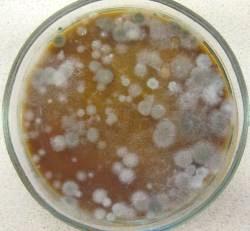
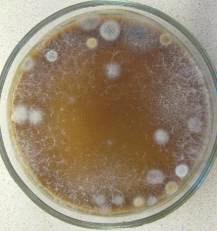

Влияние органических удобрений на микробиоту почвы
Содержание
1. Почвенные
микроорганизмы
1.1 Сапротрофная
группировка микроорганизмов
1.1.1 Бактерии
1.1.2 Грибы
1.1.3 Актиномицеты
1.1.4 Целлюлозоразрушающие
микроорганизмы
2. Роль
микроорганизмов в круговороте веществ в природе
2.1 Круговорот
азота
2.2 Роль
микроорганизмов в круговороте углерода
2.3 Превращение
микроорганизмами фосфора, железа и серы
3. Влияние
органических удобрений на микробиоту почвы
3.1 Навоз
3.1.1
Бесподстилочный навоз
3.1.2
Внесение навозных стоков
3.2 Птичий
помет
3.3 Солома
3.4 Зеленое
удобрение
3.5 Торф
Заключение
ПРАКТИЧЕСКАЯ
ЧАСТЬ
Объект
исследования
4. Методы
исследования
4.1 Определение
влажности почвы
4.2 Приготовление
почвенной суспензии и посев на питательные среды
4.3 Метод
обрастания комочков почвы
5. Учет
микроорганизмов на плотных средах
5.1 Качественная
и количественная оценка микроорганизмов на МПА
5.2 Качественная
и количественная оценка микроорганизмов на СА
6. Учет
количества микроорганизмов методом обрастания комочков почвы
6.1 Учет
количества микроорганизмов методом обрастания комочков на среде Эшби
6.2 Учет
количества микроорганизмов методом обрастания комочков на среде Гетчинсона
Заключение
Список
используемой литературы
Введение
микроорганизм удобрение
почва
Микроорганизмы почвы играют очень
важную роль в переработке значительного количества различных веществ -
минеральных и органических. Они разрушают растительные и животные остатки,
участвуют в процессах превращения продуктов их распада. При помощи
микроорганизмов изменяется структура и химический состав почвы. Микроорганизмы,
как биологические катализаторы, определяют основное свойство почвы -
плодородие. Они синтезируют и выделяют разнообразные продукты метаболизма,
которые входят в состав почвы, обуславливая ее плодородие. В процессе жизнедеятельности
все население почвы производит биохимическую работу космического значения.
Перерабатывая огромные массы органических и минеральных соединений,
микроорганизмы непрерывно синтезируют новые органические и неорганические
вещества[8].
Количественный и качественный состав
микроорганизмов в почве обусловлен содержанием в ней органических остатков,
влаги, рН, температурой, климатическими условиями и др. С увеличением
органических остатков количество микроорганизмов в почве возрастает. Больше
всего их содержится в поверхностном слое почвы, на глубине до 20 см. [8].
Почвенные бактерии играют основную
роль в минерализации органических веществ, способствуя ее самоочищению. В ходе
минерализации сложные органические вещества разрушаются до простых, например до
Н2, NH3, CO2, Н2О, и становятся доступными растениям и автотрофным
микроорганизмам. В почве протекают и процессы синтеза. Так, серо-, железо-,
водород-, метанокисляющие бактерии ассимилируют СО2 и синтезируют органические
вещества своей клетки. В ходе процессов нитрификации NH3 окисляется до нитритов
и нитратов, которые могут быть усвоены растениями. Эти процессы имеют большое
санитарное значение.
1. Почвенные микроорганизмы
Численный состав микроскопических
существ почв отличается большой динамичностью. Даже за относительно короткие
промежутки времени число микроорганизмов в почве может значительно меняться.
Это следствие динамики температуры и влажности почвы, состояния растительного
покрова и т.д. Почти во всех почвах наблюдается большая или меньшая активация
деятельности микроорганизмов весной. Очевидно, это связано с обогащением почв
отмершей за осенне-зимний период растительностью и достаточным увлажнением[3].
По мере перехода от северного климата к южному микронаселение почв возрастает;
во многих южных почвах микробиологические процессы протекают более энергично.
В таблице 1 (на стр. 8) приведены
усредненные данные о численности и соотношении основных групп сапротрофных
микроорганизмов в верхних слоях различных почв (горизонт А целинных и пахотный
слой окультуренных почв).
По данным таблицы можно сказать, что
южные зоны более богаты микроорганизмами, чем северные. Также выявляется
следующая закономерность: в почвах северной зоны спорообразующих
микроорганизмов и актиномицетов значительно меньше, чем в южных. Это
объясняется тем, что бациллы и актиномицеты размножаются на более поздних
этапах разложения растительных остатков, кроме того, северные почвы имеют
кислую реакцию, которую плохо переносят актиномицеты. В южных почвах по
сравнению с северными относительное число грибов уменьшается. Окультуренные
почвы всех зон богаче микроорганизмами, чем целинные[3].
По мере углубления в почву
значительно меняется и характер микрофлоры. В более глубоких слоях относительно
больше бацилл и актиномицетов. Это особенно заметно в черноземах и сероземах.
Таблица 1
Численность и соотношение отдельных групп
микроорганизмов в почвах разных типов (учет методом посева)
(Емцев В. Т., Мишустин Е. Н. Микробиология. 5-е
изд., перераб. и доп. М.: Дрофа, 2005)[3]
|
Зоны
|
Почвы
|
Состояние
почв
|
Общее
число микроорганизмов, тыс. на 1 г почвы
|
Бактерии,
%
|
Споры
(из числа бактерий), %
|
Актиномицеты,
%
|
Грибы,
%
|
|
Тундра
и тайга
|
Тундрово-глеевые
и глеево-подзолистые
|
Целинные
|
2140
|
95,6
|
0,7
|
1,4
|
3,0
|
|
|
Окультуренные
|
4870
|
98,0
|
0,6
|
1,6
|
0,4
|
|
Лесо-луговая
|
Целинные
|
1080
|
89,3
|
12,0
|
8,1
|
2,6
|
|
|
Окультуренные
|
2620
|
70,7
|
14,9
|
28,2
|
1,1
|
|
Луговая
степь и степь
|
Черноземы
|
Целинные
|
3630
|
63,8
|
21,4
|
35,4
|
0,8
|
|
|
Окультуренные
|
4530
|
64,4
|
24,5
|
35,1
|
0,5
|
|
Сухая
степь
|
Каштановые
|
Целинные
|
3480
|
64,8
|
19,3
|
34,7
|
0,5
|
|
|
Окультуренные
|
6660
|
67,6
|
23,0
|
32,0
|
0,4
|
|
Пустынная
степь и пустыня
|
Бурые
и сероземы
|
Целинные
|
4490
|
63,4
|
17,7
|
36,1
|
0,5
|
|
|
Окультуренные
|
7380
|
66,1
|
19,8
|
33,6
|
0,3
|
.1 Сапротрофная группировка микроорганизмов
Наиболее изучена сапротрофная группировка
микроорганизмов, т. е. микроорганизмы, разлагающие в основном легкодоступные
органические вещества. Обычно сапротрофов учитывают методом посева на твердые,
а иногда и жидкие питательные среды, содержащие те или иные органические
вещества.
.1.1 Бактерии
В составе сапротрофной микрофлоры богато
представлены бактерии, особенно неспорообразующие формы. В почвах севера, где
более медленно идет минерализация, богато представлены гнилостные бактерии
Pseudomonas fluorescens, являющиеся пионерами освоения органических
растительных остатков. В почвах юга они обнаруживаются в значительном
количестве лишь в течение краткого времени после внесения растительных
остатков. В большом числе в почвах южной зоны встречаются представители рода
Arthrobacter, характерные для более поздних стадий распада органического
вещества и предпочитающие нейтральную среду.
Бактерии Clostridium pasteurianum в больших
количествах встречаются только в северных почвах, в почвах южной зоны
доминируют C. acetobutylicum. При окультуривании почв состав почвенной
микрофлоры, в том числе бацилл и клостридий, существенно меняется, появляются
спорообразующие бактерии, свойственные более южной зоне[3].
.1.2 Грибы
Северные почвы, имеющие кислую реакцию среды,
наиболее богаты грибами. В почвах южной зоны родовой и видовой состав
микроскопических грибов более разнообразен, чем в северных. В первых доминируют
представители рода Aspergillus, а во вторых - Penicillium. Северные почвы
беднее, чем южные, грибами рода Fusarium, которые особенно обильно размножаются
в каштановых почвах и сероземах. Некоторые виды, например Fusarium sambicinum,
свойственны только щелочным почвам. Мукоровыми грибами богаты почвы северных
районов, однако некоторые роды (Choanephora, Cunninghamella, Rhizopus)
приурочены к южным почвам [3].
.1.3 Актиномицеты
Типичные формы актиномицетов, относящиеся к
аэробам и образующие мицелий, широко распространены в почве. Как и бациллы,
стрептомицеты бедно представлены в северных почвах, но в южных их численность
резко возрастает. Слабый рост актиномицетов а почвах севера может быть объяснен
как замедленным темпом разложения здесь органического вещества, так и слабой
толерантностью организмов к почвенной кислотности.
Смена состава актиномицетов в разных почвах
хорошо выявляется на примере пигментированных культур. Они гораздо больше
распространены в почвах, формирующихся в условиях теплого климата. Виды рода
Actinomadura широко распространены повсеместно, но их видовое разнообразие
значительно богаче в южных почвах[3].
.1.4 Целлюлозоразрушающие микроорганизмы
Большая часть растительных остатков состоит из
целлюлозы. Изучение микроорганизмов, разрушающих ее, показало, что их состав
существенно меняется в разных почвах. В северных почвах (тундра) этот процесс
связан с деятельностью некоторых медленно растущих грибов, главным образом
относящихся к роду Dematium и Penicillium. В зоне тайги в составе данной группы
появляются микобактерии и виды рода Cellvibrio. В южный почвах грибы в
значительной мере вытесняются выше указаннами видами бактерий и бактериями рода
Cytophaga. В заметных количествах здесь появляются грибы рода Chaetomium. [3].
2. Роль микроорганизмов в круговороте веществ в
природе
Химическая деятельность микроорганизмов
проявляется в непрерывном круговороте азота, фосфора, серы, углерода и других
веществ. При самом активном, широком участии микроорганизмов в природе, главным
образом в почве и гидросфере, постоянно осуществляется два противоположных
процесса: синтез из минеральных веществ сложных органических соединений и,
наоборот, разложение органических веществ до минеральных. Среди различных
процессов превращения веществ в природе, в которых микроорганизмы принимают
активное участие, важнейшее значение для осуществления жизни растений, животных
и человека на Земле имеют круговорот азота, углерода, фосфора, серы, железа[8].
.1 Круговорот азота
Важнейший элемент, входящий в состав белков, а,
следовательно, имеющий исключительное значение для жизни - это азот. В
круговороте азота в природе с участием микроорганизмов различают следующие
этапы: усвоение атмосферного азота, аммонификацию, нитрификацию,
денитрификацию.
Свободноживущие азотфиксаторы живут и фиксируют
азот в почве независимо от растений. Основные виды этих микроорганизмов:
Azotobacter chroococcum, Cl. pasteurianum. Азотобактер на площади в 1 га в
течение года фиксирует от 20 до 50 кг газообразного азота, повышая плодородие
почвы. Наиболее интенсивно этот процесс идет при хорошей аэрации почвы.
Клубеньковые бактерии - активные фиксаторы
атмосферного азота в симбиозе с бобовыми растениями. Наличие бактерий в
клубеньках бобовых растений установлено М. Ворониным. В чистой культуре эти
микроорганизмы выделены Бейеринком в 1888 г. и названы Bact. radicicola
(современное- род Rhizobium)[8].
Аммонификация - это минерализация азотсодержащих
органических веществ, протекающая под воздействием аммонифицирующих
микроорганизмов, выделяющих протеолитические ферменты. Благодаря аммонификации
представителей растительного и животного мира и их продуктов жизнедеятельности
(мочевины, испражнений) почва обогащается азотом и другими соединениями. К
анаэробным спорообразующим аммонификаторам относятся Cl. sporogenes.
Аммонификацию вызывают также актиномицеты, грибы, триходермы, живущие в
почве[8].
Нитрификация - следующий за аммонификацией этап
превращения азота микроорганизмами. Этот процесс представляет собой окисление
аммиака, образующегося при разложении органических азотсодержащих соединений.
Денитрификация, протекающая под воздействием
микроорганизмов, представляет собой восстановление нитратов с образованием в
качестве конечного продукта - молекулярного азота, возвращающегося из почвы в
атмосферу.[8]
.2 Роль микроорганизмов в круговороте углерода
Важнейшим элементом, входящим в состав
микроорганизмов, растений, животных, является углерод. В клеточном веществе
этот элемент составляет около 50 % сухого вещества.
Автотрофные микроорганизмы для превращения
углекислоты, не имеющей энергетических свойств, в органические энергетические
соединения нуждаются в тепловых источниках, которыми для них служит солнечная
энергия или химическая энергия окисления минеральных веществ. Усвоение углерода
с использованием солнечной энергии называется фотосинтезом, а с использованием
химической энергии - хемосинтезом. К фотоавтотрофам относят цветные бактерии:
зеленые содержат в цитоплазме хлорофилл, а пурпурные красный или коричневый
пигмент. Источником углерода для синтеза клеточного вещества у них служит углекислота.
Тионовые бактерии относятся к хемоавтотрофам, они окисляют серу до серной
кислоты. Процесс разложения органических безазотистых соединений - брожение -
возвращает углекислоту в атмосферу. В природе существует много типов брожений,
вызывающихся определенными видами микроорганизмов. Приведем только имеющие
наибольшее значение для круговорота углерода в почве[8].
.3 Превращение микроорганизмами фосфора, железа
и серы
Фосфор входит в состав белков и липидов.
Особенно много его в ядрах клеток, головном мозге человека и животных.
Микроорганизмы, участвующие в превращении фосфора, живут в почве, воде. Их роль
сводится к двум процессам: минерализации фосфора, входящего в состав
органических веществ, и превращению фосфорнокислых солей из слаборастворимых в хорошо
растворимые. Образующаяся при этом фосфорная кислота связывается со щелочами
почвы и превращается в слаборастворимые соли кальция, железа, магния и,
следовательно, малодоступные для растений.
Железо входит в состав белка гемоглобина,
содержащегося в эритроцитах. Этим объясняется его важная роль в процессе
дыхания человека и животных.
Основные представители железобактерий - нитчатые
бактерии родов Crenotrix, Chlamydothrix, Cladothrix. Эти бактерии представляют
длинные нити, покрытые общим слизистым влагалищем, в котором отлагается гидрат
окиси железа. После отмирания бактерий образуется болотная и озерная железная
руда, залегающая островами в десятки и сотни квадратных метров.
В состав белка растительного и животного
происхождения входит и сера, этим объясняется важность этого элемента в
круговороте веществ. Бактерии, усваивающие соединения серы, называют
серобактериями. Живут они в почве, воде, навозе. При разложении в почве
органических серосодержащих веществ, а также при восстановлении солей серной, сернистой
и серноватистой кислот образуется сероводород, ядовитый для растений и
животных. Этот газ превращается в безвредные, доступные для растений соединения
серобактериями[8].
3.Влияние органических удобрений на микробиоту
почвы
Органические удобрения - это разной степени
разложения органические вещества растительного, животного,
растительно-животного и промышленно-бытового происхождения; это перегной, торф,
навоз, птичий помет (гуано), различные компосты, органические отходы городского
хозяйства (сточные воды, осадки сточных вод, городской мусор), сапропель,
зеленое удобрение. Они содержат важнейшие элементы питания, в основном в
органической форме, и большое количестве микроорганизмов. Действие органических
удобрений на урожай культур сказывается в течение 3…4 лет и более[4].
.1 Навоз
Навоз - это основное органическое удобрение во
всех зонах страны. Он представляет собой смесь твердых и жидких выделений
сельскохозяйственных животных с подстилкой и без нее. В навозе содержатся все
питательные вещества, необходимые растениям, и поэтому его называют полным
удобрением. Качество навоза зависит от вида животных, состава кормов,
количества и качества подстилки, способа накопления и условий хранения.
В зависимости от способов содержания скота
различают навоз бесподстилочный (полужидкий, жидкий) и подстилочный (твердый),
получаемый при содержании скота на подстилке. Максимальной поглотительной
способностью обладают торф и солома, причем торф содержит значительно больше
азота, чем солома зерновых культур, которую чаще других применяют как
подстилку. Следовательно, торф является наилучшим подстилочным материалом.
Навоз на соломенной подстилке называют соломистым (соломенным), на торфяной -
торфяным (торфянистым).
Подстилочный навоз содержит около 25% сухого
вещества и около 75% воды. В среднем в таком навозе 0,5% азота, 0,25% фосфора,
0,6% калия и 0,35% кальция. В его состав входят также необходимые для растений
микроэлементы, в частности 30…50г марганца, 3…5г бора, 3…4г меди, 15…25г цинка,
0,3…0,5 молибдена на 1т.
Кроме питательных веществ, навоз содержит
большое количество микроорганизмов (в 1т 10-15кг живых клеток). При внесении
навоза почвенная микрофлора обогащается полезными группами бактерий.
Органическое вещество служит энергетическим материалом для почвенных
микроорганизмов, поэтому после внесения навоза в почве происходит активизация
азотфиксирующих и других микробиологических процессов.
Навоз оказывает многостороннее действие как на
почву, так и на растение. Он обогащает почву питательными элементами (азот,
фосфор, калий, кальций, магний, сера, микроэлементы и др.) повышает
концентрацию углекислого газа в почвенном и надпочвенном воздухе, снижает
кислотность почвы и подвижность алюминия, повышает насыщенность ее основаниями.
При систематическом его внесении увеличивается содержание гумуса и общего азота
в почве, улучшается ее структура, лучше поглощается и удерживается влага[7].
Содержание органического вещества в навозе
составляет 20-25 %, количество питательных веществ для растений ограничивается
долями процента (0,5 азота, 0,2% P2O5, 0,6% K2O) и около 75% воды. Органическая
часть навоза в расчете на беззольную сухую массу содержит до 40% перегнойных
соединений, около 30% целлюлозы и лигниноподобных веществ.
В навозе довольно много бактерий рода Pseudomonas,
представителей группы кишечной палочки и других неспорообразующих палочковидных
аммонификаторов. Некоторые из них могут вызывать денитрификацию. В навозе
присутствуют и гнилостные спорообразующие бактерии - Bacillus subtilis, B.
mesentericus, B. megaterium и т. д., но при холодном способе приготовления они
размножаются слабо.
В почве численность аммонифицирующих бактерии
при внесении навоза была больше по сравнению с минеральными удобрениями в 2…4
раза, маслянокислых бактерий - в 4…5 раз, целлюлозоразрушающих бактерий - в 3…4
раза, а в прикорневом слое эти различия были ещё больше: аммонифицирующих
бактерий было больше в 5…6 раз, маслянокислых бактерий - в 3…9 раз,
целлюлозоразрушающих микроорганизмов - в 3…16 раз, нитрифицирующих - в 4…10 раз
(таблица 2)
Под влиянием органического вещества навоза
усиливаются микробиологические процессы в почве, в результате повышается
растворимость, следовательно, и доступность растениям элементов минерального
питания. Например, нерастворимые фосфаты кальция, железа, алюминия и другие
формы переходят в соединения, усвояемые растениями. Фосфор же, потребленный
микроорганизмами и закрепленный в плазме при их отмирании, переходит в
легкоусвояемые растениями соединения[7].
Таблица 2
Влияние последействия навоза на динамику численности
микроорганизмов при возделывании ячменя в звене севооборота,
тыс/г абсолютно сухой почвы [5]
|
Вариант
|
В
почве в фазу
|
В
прикорневом слое почвы в фазу
|
|
Кущения
|
Выхода
в трубку
|
Созревания
|
Кущения
|
Выхода
в трубку
|
Созревания
|
|
Аммонифицирующие
бактерии
|
|
15NPK
|
7900
|
5300
|
7600
|
700
|
30000
|
34000
|
|
15N
навоза
|
14200
|
13800
|
27400
|
42000
|
145000
|
150000
|
|
Маслянокислые
бактерии
|
|
15NPK
|
140
|
64
|
120
|
140
|
110
|
260
|
|
15N
навоза
|
1300
|
260
|
760
|
4200
|
950
|
420
|
|
Целлюлозоразрушающие
микроорганизмы
|
|
15NPK
|
8
|
22
|
5
|
15
|
50
|
|
15N
навоза
|
22
|
42
|
56
|
85
|
140
|
154
|
|
Нитрифицирующие
бактерии
|
|
15NPK
|
29
|
45
|
106
|
30
|
27
|
38
|
|
15N
навоза
|
40
|
150
|
470
|
88
|
118
|
406
|
.1.1 Бесподстилочный навоз
Бесподстилочный навоз значительно активизирует
размножение всех изучаемых групп микроорганизмов, с деятельностью которых
связаны процессы трансформации органического вещества навоза и почвы.
Увеличение численности микроорганизмов зависит от вносимой дозы
бесподстилочного навоза. Численность аммонифицирующих бактерий увеличилась в
2,5…30 раз в среднем за вегетацию, нитрифицирующих - в 3…5 раз,
динитрифицирующих - в 5…20 раз, грибов - в 2…6 раз, актиномицетов - в 2…7 раз.
Систематическое внесение возрастающих доз
бесподстилочного навоза приводит к снижению биологической активности почвы.
Причиной этого может быть изменение физико-химических свойств почвы, поскольку
с бесподстилочным навозом вносится большое количество воды (особенно при
внесении больших доз навоза), что приводит к переувлажнению почвы и созданию
более анаэробных условий. Активнее размножаются денитрифицирующие бактерии.
Наиболее эффективно применение бесподстилочного
навоза в дозах 200…300 кг/га азота, внесение более высоких доз бесподстилочного
навоза следует считать нерациональным, поскольку урожай возделываемых культур
при этих дозах не повышается, ухудшаются биологические свойства почвы[5].
.1.2 Внесение навозных стоков
На животноводческих комплексах накапливаются не
только большие количества жидкого бесподстилочного навоза, но также и большие
объемы навозных стоков влажностью 97-98%. Их обычно используют в больших дозах
для орошения кормовых культур[5].
При внесении навозных стоков в почву содержание
аммиачного азота повышено, что вредит растениям, а нитратный азот представлен
практически только азотом из почвы. В плодородной почве спустя месяц после
внесения стоков уровень нитратного азота возрастает в 6-10 раз.
При внесении навозных стоков в почве с
повышенным плодородием мобилизация органического вещества идет более
интеренсивно, чем в менее плодородной почве. Численность аммонифицирующих
бактерий в плодородной почве выше в 3…5 раз, нитрифицирующих - в 3…7 раз,
целлюлозоразрушающих - в 2…5 раз в среднем за вегетацию по сравнению с менее
плодородной почвой.
Нужно сказать, что высокие дозы навозных стоков
могут отрицательно влиять на экологию - нитратный азот теряется с промывными
водами. Следовательно, навозные стоки нужно применять под культуры, способные
активно использовать азот[5].
Большие размеры содержания и вымывания азота
коррелируют с повышенной численностью аммонифицирующих, нитрифицирующих бактерий,
участвующих в трансформации органического вещества почвы и навозных стоков.
.2 Птичий помет
Это ценное наиболее концентрированное
быстродействующее органическое удобрение, содержащее в подстилочном виде
30-50%, а в подстилочном - около 10% аммиачного азота от общего содержания
азота.
Подстилочный куриный помет обладает достаточной
сыпучестью, невысокой влажностью; применяется как подстилочный навоз в дозах,
рассчитанных по азоту[4].
Бесподстилочный помет - липкая мажущаяся масса с
более высоким, чем в подстилочном помете, содержанием питательных элементов,
однако содержит много семян сорняков, яиц и личинок гельминтов и мух и
различных микроорганизмов, многие из которых - возбудители болезней. Для его
обеззараживания, сохранения питательных элементов, улучшения
физико-механических свойств применяют быструю термическую просушку при
600-800°С. При такой сушке влажность его снижается до 20%, потери азота не
превышают 5%, масса уменьшается, а концентрация питательных веществ возрастает
примерно в 3 раза по сравнению с исходной[7].
Куриный помет по своим удобрительным качествам
превосходит навоз, а по быстроте действия не уступает минеральным удобрениям.
Помет гусей и уток более водянист и по содержанию питательных веществ
приближается к обычному навозу[10].
В свежем курином помете, как правило, нет
летучих форм азота, но при хранении в кучах он сильно разогревается и
вследствие энергичного превращения мочевой кислоты в аммиачные соединения азот
теряется. Потери азота при таком хранении за 1,5-2 месяца могут достигать
30-60% от общего его содержания в помете. Эти потери можно устранить, если
свежий помет компостировать с торфом, перегноем, соломой, опилками, дерниной и
даже с почвогрунтом[4].
Пометные удобрения целесообразно использовать в
первую очередь под пропашные, затем под озимые и травы в качестве основного
удобрения и в подкормки. В районах достаточного увлажнения помет и его компосты
можно заделывать дисковыми орудиями и культиваторами, на песчаных и супесчаных
почвах более эффективно запахивание компостов[10].
Пометные компосты по эффективности не уступают
подстилочному навозу, а в отдельных случаях его превосходят.
.3 Солома
Излишки соломы в качестве удобрения обогащают
почву и возделываемые на ней культуры органическим веществом и питательными
элементами. Солома при влажности 16% содержит в среднем 0,5% N, 0,25 P2O5, 1,0%
K2O и 35-40% углерода, а также небольшие количества кальция, магния, серы и
микроэлементов. Соотношение C:N в соломе очень широкое (60-100), поэтому
разлагающие органическое вещество микроорганизмы нуждаются в дополнительном
питании азотом, который перехватывают у растений из почвы и удобрений. Для
предотвращения этого при запашке нужно дополнительно вносить 0,5% азота от ее
массы в виде минеральных или органических удобрений[6].
Солома улучшает физико-химические свойства
почвы, предотвращает вымывание водорастворимых форм азота и других элементов,
повышает биологическую активность почвы, доступность растениям питательных
элементов почвы и удобрений[11].
Солома - активный энергетический материал для
образования гумуса почвы и повышения микробиологической активности почвы.
Солома содержит около 15% воды и примерно на 80%
состоит из органического вещества. Целлюлоза, пентозаны, гемицеллюлоза и лигнин
(до 80%) является энергетическим материалом для микроорганизмов почвы, а
продукты их деструкции - строительным материалом для лабильного гумуса. В
среднем количество гемицеллюлозы в составе растительных остатков составляет
15-20%, лигнина - 15-22%. За 20-30% лигнина процесс расщепления целлюлозы
значительно замедляется. Солома в почве превращается: в ней сначала разлагаются
простые углеводы, гемицеллюлоза, белковые соединения, а затем целлюлоза и
лигнин. Химический состав соломы значительно изменяется в зависимости от
свойств почвы и погодных условий. В среднем солома содержит 0,5% азота, 0,25 -
фосфорного ангидрида, 0,8 - окиси калия и 35-40% органического углерода, 25 г
бора, 15 - меди, 150-марганца, 2 - молибдена, 200 - цинка и 0, 5 г
кобальта[11].
Целлюлозоразлагающие микроорганизмы испытывают
сравнительно высокую потребность в азоте. Учитывая небольшое количество его в
соломе, микроорганизмы потребляют минеральный азот из почвы, т.е. идет процесс
иммобилизации азота. Если азота почвы ограниченное количество, то тормозятся
процессы разложения соломы. Установлено, что для нормального протекания
процессов разложения соломы отношение C:N должно быть 20…30. Более узкое
соотношение этих элементов приводит к минерализации азотистых соединений, а
более широкое - усиливает процессы иммобилизации азота. В связи с широким
соотношением в соломе С:N - 70…80, после ее разложения микроорганизмы
потребляют минеральный азот[6].
Особое значение удобрение соломой имеет для
бобовых культур, фиксирующих молекулярный азот атмосферы. Поэтому на площадях,
удобренных соломой, желательно размещать в первую очередь бобовые или пропашные
культуры[3].
Некоторые продукты разложения соломы токсичны
для растений. Особенно много вредных соединений накапливается при анаэробном
разложении соломы. В аэробных условиях и в почвах с высокой биологической
активностью токсичные соединения разлагаются быстрее.
Все это и многое другое свидетельствует о
необходимости широкого использования на удобрение излишков соломы в качестве
важного источника гумуса почвы, как фактора ее плодородия[11].
.4 Зеленое удобрение
Зеленые удобрения - свежая растительная масса,
запахиваемая в почву для обогащения ее и последующих культур органическим
веществом и питательными элементами, главным образом азотом, улучшения водного,
воздушного и теплового режимов. Растения, выращиваемые на зеленые удобрения,
называют сидератами. Наибольшее значение зеленое удобрение имеет на
малоплодородных дерново-подзолистых, песчаных, суглинистых и супесчаных почвах,
а также на орошаемых землях и во влажных районах Закавказья[4].
В качестве сидератов чаще всего используют
бобовые (люпин, сераделла, донник, вика, чина), реже - смеси бобовых со злаками
или промежуточные небобовые культуры (горчица, сурепица, рапс и др.).
Дополнительное обогащение почв и растений азотом в значительных количествах
наблюдают при бобовых сидератах, обладающих симбиотической азотфиксацией
атмосферного азота.
В сравнении с содержанием в 1 т смешанного
навоза плотного хранения бобовые сидераты богаче азотом, но беднее фосфором и
калием. Смеси бобовых со злаками, а также небобовые сидераты, естественно,
беднее и азотом.
Процессы разложения зеленых удобрений в почве
протекают значительно быстрее, чем других органических удобрений, богатых
медленно разлагающимися веществами.
Важнейшее условие повышения эффективности
зеленого удобрения - это правильно сочетание его с другими органическими и
минеральными удобрениями и химической мелиорацией почв. Такой способ удобрения
широко применяется, так как он дешев (часто не требует транспортных средств), и
по химическому составу зеленое удобрение близко к навозу[7].
Зеленое удобрение - важнейший источник гумуса и
азота в почве. При запашке высоких урожаев зеленой массы сидератов 35- 40 т/га
в почву попадает 150-200 кг азота, что равноценно 30-40 т навоза. Коэффициент использования
азота зеленого удобрения (в первый год действия) вдвое выше, чем такой же
коэффициент навоза. Бобовые сидераты обогащают пахотный слой почвы усвояемым
фосфором, калием и другими элементами[7].
Применение зеленых удобрений в чистом виде и в
сочетании с соломой приводило и к изменению видового состава спорообразующих
бактерий на опытных полях Тимирязевской сельскохозяйственной академии. При
запашке зеленого удобрения и соломы растет доля бацилл, использующих
минеральный азот почвы, что является показателем интенсивно идущего процесса
разложения органического материала[12].
Особенно высокая эффективность от зеленых
удобрений наблюдается на легких песчаных почвах с плохими агрохимическими,
физико-химическими, биологическими и водными свойствами[4].
.5 Торф
Это удобрение представляет собой смесь
полуразложившихся в условиях избыточного увлажнения остатков растений, в
основном болотных. Торф может быть низкой степени разложения (до 20%), средней
(20-40%) и высокой (более 40%). Широко применяют в сельском хозяйстве как
удобрение[7].
Различают три типа торфа: верховой, низинный и
переходный.
Верховой торф образуется на бедных питательными
веществами возвышенных метах рельефа (сфагновые мхи, пушицы, шейхцерия
болотная, подбел, багульник, осока топяная и др.). Верховой торф
характеризуется повышенным количеством органического вещества, высокой
кислотностью, большой поглотительной способностью и малым содержанием
питательных веществ. Применяют указанный торф главным образом в качестве
подстилки и для компостирования[4].
Низинный торф образуется на богатых питательными
веществами пониженных частях рельефа (осоки, гипновые мхи, тростник, хвощ,
таволга, сабельники и др.). Низинный торф содержит больше питательных веществ и
меньше органического вещества, чем верховой. Наиболее целесообразно его
использовать для приготовления различных компостов.
Переходной торф занимает промежуточное положение
между верховым и низинным. По количеству золы торфа подразделяют на нормальные
(до 12%) и высокозольные (более 12%).
Торф, как правило, имеет кислую реакцию, с pH
5,5 и менее даже низинный разложившийся торф нельзя использовать как удобрение
без предварительного компостирования с известью, фосфоритной мукой, золой,
навозом, жижей и т. д [7].
Заключение
Процессы минерализации вносимых в почву
органических удобрений, синтез и разложение гумуса, уровень минерального
питания растений в результате разложения органического вещества зависят от
характера и направленности протекающих в почве микробиологических процессов.
Органические удобрения имеют долгое
последействие за счет того, что органические соединения высокомолекулярны, и
микроорганизмам требуется много времени, чтобы их ассимилировать.
Микробиологические процессы идут постоянно, переходя от одного этапа к другому
по кругу, каждый раз переводя органические соединения в минеральные, а
минеральные обратно в органические.
Минеральные удобрения тоже активизируют
микробиоту почвы, усиливают распад гумуса, увеличивают мобилизацию азота,
фосфора и других элементов. Однако их приходится вносить каждый год, так как
минеральная форма азота активнее потребляется растениями и уносится с урожаем,
за один вегетационный период расходуется полностью.
Внесение в почву минеральных и органических
удобрений усиливает интенсивность микробиологических процессов, в результате
чего увеличивается трансформация органических и минеральных веществ.
ПРАКТИЧЕСКАЯ ЧАСТЬ
Объект исследования
Для микробиологических исследований был
использован чернозем южный. Южные черноземы формировались под
типчаково-ковыльной растительностью в южной части степной зоны. Область
распространения южных черноземов представляет собой на западе выположенную
пониженную равнину, переходящую затем в ряд повышенных равнин и участков с
наличием сопочных массивов на фоне равнинной местности.
Почвообразование происходит на лёссах и
лёссовидных породах, на бурых и красно-бурых тяжелых суглинках, на сыртовых
суглинках, содержащих до 5% карбонатов и легкорастворимые соли, на коренных
породах (известняках) и продуктах разрушения коренных и осадочных пород.
Профиль почв имеет следующее морфологическое
строение:
А - гумусовый горизонт мощностью 20-30 см,
темно-серый с коричневатым оттенком, в целинном состоянии вверху часто
обособляется слой в 6-8 см, более светлоокрашенный, слоеватый; структура зернистая,
при распашке - комковато-пылеватая. Вскипание начинается на нижней границе
горизонта, пахотные почвы часто вскипают с поверхности;
АВ - переходный гумусовый горизонт мощностью
30-40 см, однородно окрашенный, буровато-темно-серый, зернисто-комковатой или
ореховато-комковатой структуры. Уплотнен.
Общая мощность гумусовых горизонтов колеблется
от 25-30 до 60-70 см, в отдельных случаях - до 100 см;
Вк - переходный горизонт, бурый с более темными
пятнами и потеками гумуса, ореховато-призматической структуры, уплотнен;
выделения карбонатов в виде псевдомицелия, в нижней части в виде белоглазки,
могут быть в виде неясных выцветов, мучнистых выделений;
ВСК - иллювиально-карбонатный горизонт,
буровато-палевый, призматической структуры, уплотнен, с обильными выделениями
карбонатов в форме белоглазки;
Ск - слабо измененная или не измененная
почвообразованием материнская порода, карбонатная, палевого цвета,
призматической структуры;
Сс - материнская порода, содержащая с глубины
150-200 см выделения гипса в виде мучнисто-кристаллических жилок, скоплений и
друз; в этом же горизонте на глубине 200-300 см могут содержаться
легкорастворимые соли.
В профиле почв встречаются кротовины.
Содержание гумуса может достигать 4-7%, падение
его содержания с глубиной постепенное. В составе гумуса преобладают гуминовые
кислоты, прочно связанные с кальцием, отношение Сг:Сф>1,5. Емкость
поглощения высокая (35-45 мг-экв на 100 г почвы). Реакция среды в верхней части
гумусового горизонта близка к нейтральной (pH 7,0-8,0), книзу подщелачивается.
Распределение ила и валового химического состава по профилю почв
характеризуется относительной однородностью.
4. Методы исследования
.1 Определение влажности почвы
Для определения влажности почвы мы
отобрали из средней пробы 5 г исследуемой почвы. Для пересчета результатов на 1
г абсолютно сухой почвы, взвесили пустой бюкс, определив параметр a, взвесили
бюкс с сырой почвой, определив параметр b. Высушили бюкс с навеской почвы в
сушильном шкафу при 105
 до достижения постоянной массы, а
затем взвесили бюкс с абсолютно сухой почвой, определив параметр c. Определили
содержание абсолютно сухой почвы в 1 г сырой по формуле:
до достижения постоянной массы, а
затем взвесили бюкс с абсолютно сухой почвой, определив параметр c. Определили
содержание абсолютно сухой почвы в 1 г сырой по формуле:

а=23,8г, b=28,8г, c=28,0г;

.2 Приготовление почвенной суспензии
и посев на питательные среды
Навеску почвы перенесли в колбу,
емкостью 250 мл, содержащую 90 мл стерильной воды, поставили на ротатор, в
течение 10 минут и дали отстояться в течение 5 минут.
Затем мы методом разведения
приготовили почвенные суспензии, содержащие разное количество почвы. 1 мл
суспензии в колбе соответствует разведению 10-1. Чтобы получить следующие
разведения, мы взяли из колбы 1 мл суспензии и прилили в пробирку, где было 9
мл стерильной воды, затем из первой пробирки взяли 1 мл и прилили в следующую и
так далее, до четвертой пробирки. В пробирках соответственно у нас получились
разведения 10 -2, 10-3, 10-4 и 10-5.
Первые два разведения не используют
для посева, а четвертое и пятое мы использовали для посева на среды МПА
(мясо-пептонный агар) и СА (сусло-агар) методом питательных пластин (метод
Коха). Для глубинного посева мы взяли 1 мл почвенной суспензии, внесли в
стерильную чашку Петри, залили агаром, расплавленным и охлажденным до 45
 , и перемешали круговыми движениями.
, и перемешали круговыми движениями.
.3 Метод обрастания комочков почвы
Если численность каких-либо групп
микроорганизмов в почве небольшая, то выявить их численность можно методом
обрастания комочков. Для этого мы использовали среды Гетчинсона и Эшби. Мы
взяли почву из образца и разложили его комочками по всей поверхности
питательных сред и убрали в термостат с температурой 26
 .
.
Каждый посев производится в
двукратной повторности.
5. Учет микроорганизмов на плотных
средах
.1 Качественная и количественная
оценка микроорганизмов на МПА
На МПА выявляют микроорганизмы,
использующие органические формы азота - аммонификаторы.
После инкубации мы вынули чашки с
засеянными средами из термостата и подсчитали число колоний, которые отражают
число живых клеток микроорганизмов в почве. После подсчета количества всех
колоний на чашке мы их сгруппировали по культуральным признакам: характеру
роста на агаре, цвету, краю, форме, размеру (приблизительный) и консистенции
колонии - для качественного анализа сапротрофной микрофлоры на МПА. Мы выбрали четвертое
разведение, потому что колонии на среде были выделены более четко и не
перекрывались друг другом.
Табл. 3
Количественная оценка
микроорганизмов на МПА
|
Разве-дение
|
Общее
КОЕ (ср. из 2х повторнос-тей) в чашке
|
Количество
микроорганиз-мов КОЕ/1 г абсолютно сухой почвы
|
Число
доминирующих КОЕ (ср. из 2х повторностей)
|
Доминирующие
формы КОЕ/1 г абсолютно сухой почвы
|
Доминирующая
форма и её содержание (%)
|
|
10-4
|
79
|
64×104
|
48
|
39×104
|
60,8
%
|
Количество микроорганизмов в 1 г абсолютно сухой
почвы:
79×104/ 0,81 = 64×104
Количество микроорганизмов доминирующей формы в
1 г абсолютно сухой почвы:
48×104/0,81 =39×104
Доля доминирующих форм в общей численности
микроорганизмов:
64×104/39×104×100%
= 60,8 %
Табл. 4
Культуральные и морфологические признаки доминирующих
микроорганизмов
|
Культуральные
признаки
|
Морфологические
признаки
|
Предполагаемый
род, к которому можно отнести описываемый микроорганизм
|
|
Форма
колонии: округлая; цвет: кремовый; блеск: матовый; поверхность: гладкая;
край: ровный; структура: однородная; консистенция: плотная.
|
 Рис.
1.бактерии рода Bacillus под микроскопом, ×1600 Форма
клетки: палочковидная; Характер расположения клеток: поодиночке; Способность
к спорообразованию: спорообразующие Рис.
1.бактерии рода Bacillus под микроскопом, ×1600 Форма
клетки: палочковидная; Характер расположения клеток: поодиночке; Способность
к спорообразованию: спорообразующие
|
р.
Bacillus
|
Качественная и количественная оценка
микроорганизмов на СА
Среду сусло-агар применяют для учета
микроскопических грибов. Учет проводят аналогично предыдущему.
В нашем образце были обнаружены грибы рода
Penicillium и Aspergillus, но Aspergillus по численности преобладал.
Табл. 5
Количественная оценка микроорганизмов на СА
|
Разве-дение
|
Общее
КОЕ (ср. из 2х повторнос-тей)
|
Количество
микроорганиз-мов КОЕ на 1 г абсолютно сухой почвы
|
Доминирующие
формы КОЕ на 1 г абсолютно сухой почвы
|
Доля
доминирующих форм и их процентное содержание
|
|
10-3
|
16
|
13×103
|
14
|
11,3×103
|
87,5
%
|
Количество микроорганизмов в 1 г абсолютно сухой
почвы:
16×103/0,81 = 13×103
Количество микроорганизмов доминирующей формы в
1 г абсолютно сухой почвы:
14×103/0,81
=11,3×103
Доля доминирующих форм в общей численности
микроорганизмов:
13×103/11,3×103×100%=
87,5%

Рис. 2 Среда СА, разведение вытяжки 10-2 Рис. 3
Среда СА, разведение вытяжки 10-3
Табл. 6
Культуральные и морфологические признаки
доминирующих микроорганизмов.
|
Культуральные
признаки
|
Морфологические
признаки
|
Предполагаемый
род, к которому можно отнести описываемый микроорганизм
|
|
Форма
колонии: округлая; размер: 6 мм - 8 см; цвет: черный; блеск: отсутствует;
поверхность: бархатистая; край: зубчатый; структура: однородная.
|
 Рис. 4
гриб рода Aspergillus,
×64
Выявлен мицелий и споры Рис. 4
гриб рода Aspergillus,
×64
Выявлен мицелий и споры
|
р.
Aspergillus
|
6. Учет количества микроорганизмов методом
обрастания комочков почвы
Этот метод используется для определения
относительной оценки плотности заселения аэробными азотфиксирующими
микроорганизмами путем раскладывания комочков почвы.
.1 Учет количества микроорганизмов методом
обрастания комочков на среде Эшби
Среда Эшби не содержит ни минеральных, ни
органических форм азота, поэтому ее используют для учета азотфиксирующих
микроорганизмов.
При учете численности микроорганизмов мы
посчитали обросшие колониями комочки почвы и, зная общее количество комочков,
посчитали процентное содержание обросших комочков.
Табл. 7
Учет доли обросших комочков почвы на среде Эшби
|
Общее
число комочков
|
Количество
обросших комочков
|
%
обросших комочков от общего числа.
|
|
50
|
33
|
66%
|

Рис. 5 Комочки почвы на среде Эшби через неделю
после посева
Колонии азотобактера - плоские, слизистые,
мажущиеся консистенции, пигментированные, отмечается образование коричневого
пигмента.

Рис. 6 Бактерии рода Azotobacter, культура
полученная методом обрастания комочков почвы, ×1600
.2 Учет количества микроорганизмов методом
обрастания комочков на среде Гетчинсона
На среде Гетчинсона выявляют
целлюлозоразрушающие микроорганизмы. Эта среда не содержит никаких источников
углерода, кроме целлюлозы в виде фильтровальной бумаги. Другие микроорганизмы,
не разлагающие целлюлозу, не могут развиваться, так как не имеют альтернативных
источников углерода.
Табл. 8
Учет доли обросших комочков на среде Гетчинсона
|
Общее
число комочков
|
Количество
обросших комочков
|
%
обросших комочков от общего числа.
|
|
50
|
32
|
64%
|

Рис. 7 Обросшие комочки почвы на среде
Гетчинсона
В чашке Петри замен значительный рост
бактериальных колоний, но выявить их род не удалось из-за обильного роста
целлюлозоразрушающих грибов.

Рис. 8 Преперат гриба, выделенный на среде
Гетчинсона, предположительно род Dematium, ×1600
Заключение
В полученном образце южного чернозема в ходе
микробиологического анализа были обнаружены микроорганизмы рода Bacillus, как
доминирующий вид, играющий одну из главных ролей в процессе минерализации
органических соединений азота. Также были обнаружены различные формы микроскопических
грибов (р. Aspergillus и Penicillium), что свидетельствует о слегка повышенной
кислотности почвенного образца. А также о большом процентном содержании гумуса,
и, как следствие, о повышенном плодородии почвы. Также в исследуемом образце
был найден Azotobacter, а значит процесс азотфиксации протекает достаточно
интенсивно, и о том, что кислотность нормальная для развития требовательного
азотобактера.
Таким образом, данный образец почвы подходит для
выращивания сельскохозяйственных культур, так как в почве протекают все
необходимые для развития растений микробиологические процессы, а именно -
минерализация органического вещества, азотфиксация. Почва содержит достаточное
количество питательных веществ.
Список используемой литературы
Аристовская
Т. В. Микробиология процессов почвообразования. Л.: Наука, 1980
Бабьева
И. П., Зенова Г. М. Биология почв. М.: МГУ, 1989
Емцев
В. Т., Мишустин Е. Н. Микробиология. 5-е изд., перераб. и доп. М.: Дрофа, 2005
Минеев
В. Г. Агрохимия 3-е изд. перераб. и доп. М.: МГУ, 2005
Минеев
В.Г., Ремпе Е.Х. Агрохимия, биология и экология почвы. М Росагропромиздат
1990г.
Мишустин
Е. Н., Емцев В. Т. Микробиология. 3-е изд., перераб. и. доп. М.: Агропромиздат,
1987
Ягодин
Б. А., Жуков Ю. П., Кобзаренко В. И. Агрохимия/ Под ред. Б. А. Ягодина. М.:
Колосс, 2002